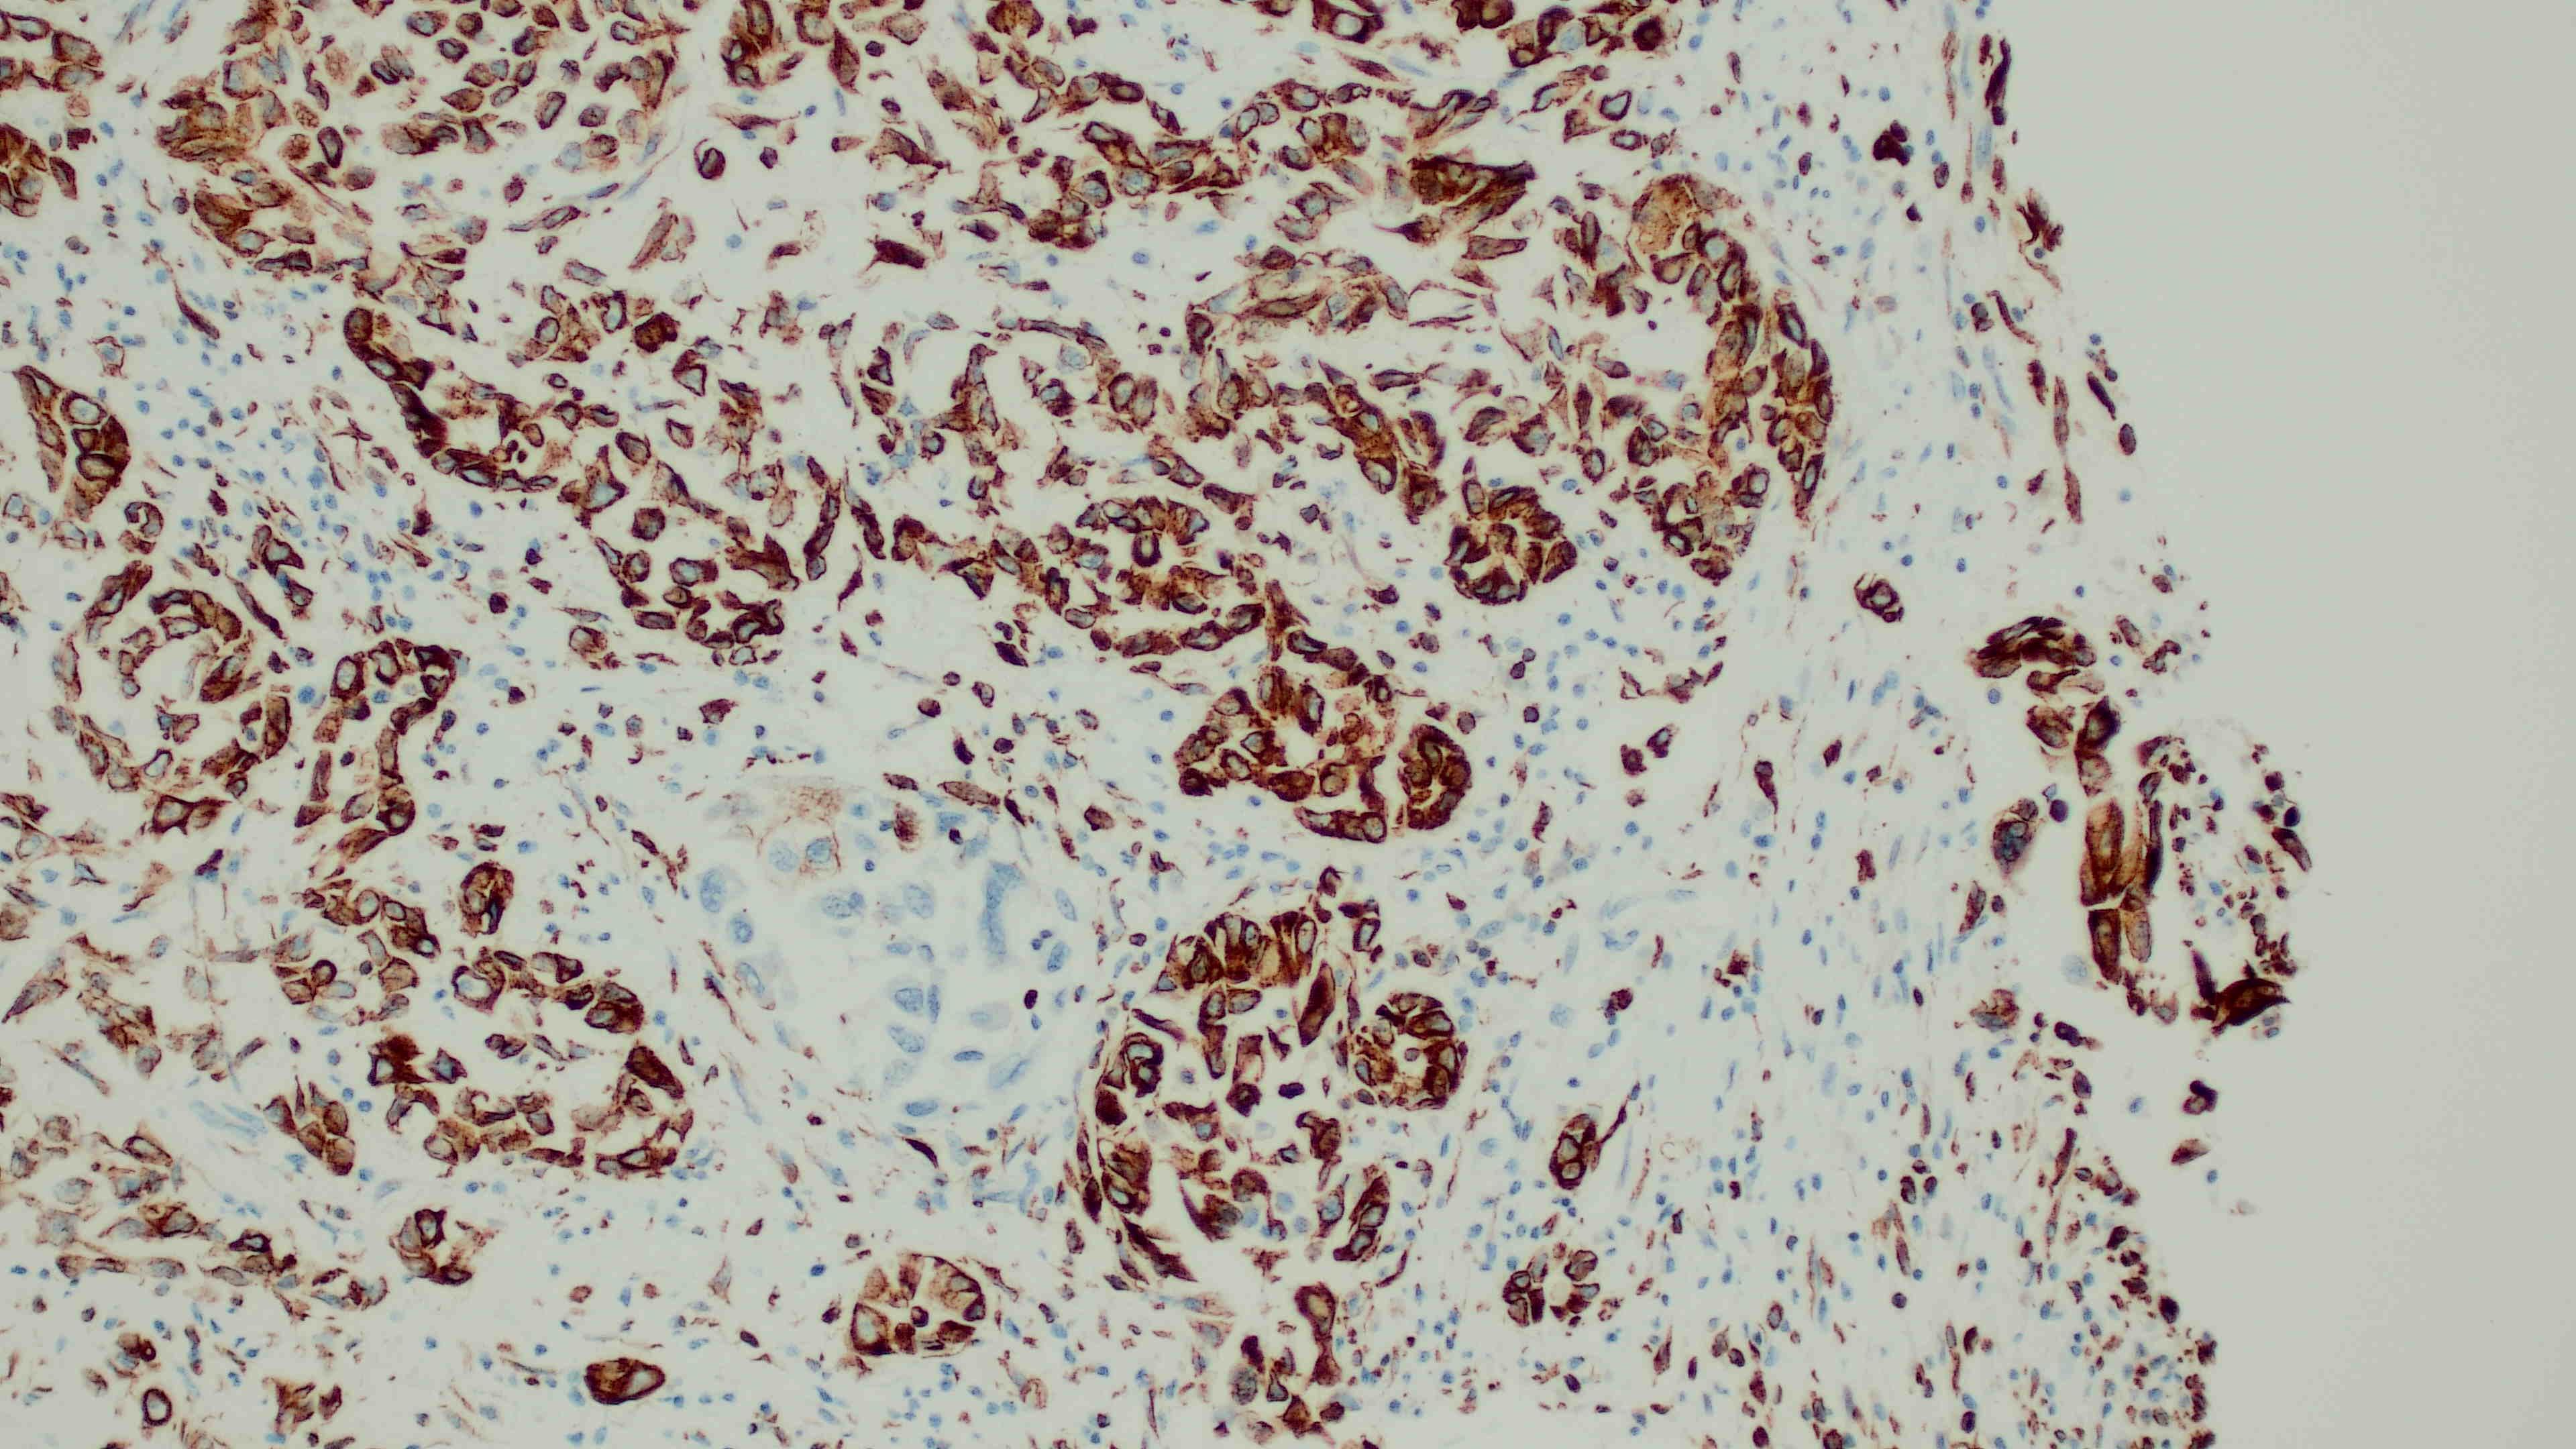

Conference 14, Case 3
Signalment:
33-year-old, female intact donkey (jenny), Equus asinus)
History:
1-week history of weight loss. There was an acute decline over 24 hours with depression and anorexia. Physical exam revealed a heart rate of 88bpm, ileus, and delayed capillary refill time. ICU care was offered but, due to the poor prognosis, the owners opted to euthanize.
Gross Pathology:
Externally the animal was emaciated. There was 24.5L of red watery peritoneal fluid, and 500ml of red watery pleural fluid. There were multifocal to coalescing exophytic, papillary, white nodules ranging from pinpoint to 5x5x2cm on the abdominal and thoracic body walls, the diaphragm, the omentum, the mesentery, the lung, the liver, the spleen, the peri-renal adipose tissue, and the ovary. The nodules were frequently associated with multifocal to coalescing hemorrhages.
Laboratory Results:
N/A
Microscopic Description:
Extending from and infiltrating the omentum is an unencapsulated, poorly demarcated, moderately cellular neoplasm composed of cuboidal to polygonal cells arranged in acini, tubules and nests, and more rarely micropapillary projections, on a moderate fibrovascular stroma. Neoplastic cells have variably distinct cell borders, an abundant amount of granular, eosinophilic and occasionally indistinctly vacuolated cytoplasm, and a pleomorphic, centrally placed nucleus with finely stippled to marginated chromatin and up to 3, occasionally very large distinct magenta nucleoli. There is marked anisocytosis and anisokaryosis, and 21 mitotic figures in 2.37mm2 – equivalent of 10 high power fields (40x obj); these are occasionally bizarre. There are occasional multinucleated neoplastic cells with up to 3 nuclei which occasionally compress and occasional apoptotic bodies are seen. Multifocally, neoplastic stroma contains minimal extravasations of erythrocytes (haemorrhage), and there are multifocal mild infiltrations of deform adjacent nuclei (nuclear molding).
There is occasional single cell necrosis, andmainly mature small lymphocytes, some plasma cells, and fewer neutrophils. Blood vessels are multifocally moderately congested and are often lined by plump (reactive) endothelium.
Immunohistochemistry: Neoplastic cells are diffusely strongly positive for vimentin. The majority of neoplastic cells are moderately positive for cytokeratin.
Contributor’s Morphologic Diagnoses:
Pleural and peritoneal cavities: Mesothelioma, epithelioid subtype.
Contributor’s Comment:
Postmortem examination revealed the presence of a neoplastic process within the pleural and peritoneal cavity, which on histopathology had a morphology most likely consistent with a mesothelioma.3,12 Additionally, the immunopositivity of both cytokeratin and vimentin, is consistent with a mesothelial origin, although rarely this dual positivity can be present in metastatic ovarian or renal carcinomas, which were not identified in this case.12
Mesotheliomas are considered rare and affect many animal species; they are most commonly reported in cattle, which have a congenital form, and in canines.4,8,9,17 They have also been reported in goats, cats, sheep, horses, jaguars, skunks, and amazon parrots.5,6,11,13-15 They should be differentiated from mesothelial hyperplasia using the features in Table 1, taken from Husain et al., 2018.3 This case displays a moderate amount of fibrovascular stroma with invasion, contains complex tubular and micropapillary structures with disorganized growth, and only a mild inflammation which is consistent with mesothelioma.3
Confirmed cases are unreported in donkeys, however, there are suggested similarities in neoplastic diseases in donkeys and horses.1 Most diagnoses are made postmortem.12
Mesotheliomas can be classified as:
- Epithelioid (most common, better prognosis): Small oval to cuboidal cells shape that connect often forming small tubular or papillary structures;
- Sarcomatoid or Fibrous: fusiform cells that do not connect or form structures and widely infiltrate surrounding tissue; or
- Mixed or Biphasic: contains at least 10% of each cell type (epithelioid and sarcomatoid cells).3,12
In humans and dogs further subclassification can be performed with 17 subtypes, and stroma can contain chondroid or osseous differentiation, due to the multipotency of mesothelial cells.3,12 In humans, canines and bovines, mesothelioma has been associated with asbestos fiber inhalation.2,4,8
Calretinin, where commercially available, can be a useful addition to an immunohistochemistry panel for suspected mesothelioma in horses, and may be useful in the donkey, in addition to vimentin and cytokeratin.16
Looking at the ultrastructure may aid diagnosis, particularly where concern remains for malignant carcinomas. Neoplastic epithelioid mesothelial cells have abundant, long, occasionally branching microvilli, and circumferential nuclear intermediate microfilaments.3
Table 1: Reactive Mesothelial Hyperplasia Versus Mesothelioma (taken from Husain et al., 2018)3
|
Mesothelial hyperplasia |
Mesothelioma |
|
Absence of stromal invasion (beware of entrapment and en face cuts) |
Stromal invasion usually apparent (highlight with pancytokeratin staining) |
|
Cellularity may be prominent but is confined to the mesothelial surface/ pleural space and is not in the stroma |
Dense cellularity, including cells surrounded by stroma |
|
Simple papillae, single cell layers |
Complex papillae, tubules and cellular stratification |
|
Loose sheets of cells without stroma |
Cells surrounded by stroma (‘‘bulky tumor’’ may involve the mesothelial space without obvious invasion) |
|
Necrosis rare |
Necrosis present (occasionally) |
|
Inflammation common |
Inflammation usually minimal |
|
Uniform growth (highlighted with cytokeratin staining) |
Expansile nodules; disorganized growth (highlighted on cytokeratin staining) |
|
Usually not useful |
|
|
Mitotic activity Mild to moderate cytology’s atypia |
|
Contributing Institution:
Veterinary Pathology Service
University of Nottingham
Sutton Bonington Campus
College Road
Sutton Bonington
Leicestershire
United Kingdom
LE12 5RA
https://www.nottingham.ac.uk/vet/service-for-business/veterinary-pathology-service/index.aspx
JPC Diagnosis:
Omentum: Mesothelioma.
JPC Comment:
This third case was challenging due to the epithelioid nature of this mesothelioma. Most conference participants were readily able to reach a diagnosis of “carcinoma” or “adenocarcinoma” and many listed epithelioid mesothelioma as a differential. Tissue identification was challenging and only the most experienced participants felt confident calling it omentum based off the HE secttion. The features described by these participants that clued them in to “omentum” included a nodular “string of pearls” subgross appearance, the composition of a highly vascular fibroadipose tissue, and the wherewithal to remember that the omentum exists in the first place, which can be challenging in and of itself some days. The contributor provided a succinct, eloquent write-up on mesotheliomas and their classifications, which were covered during the conference discussion.
An interesting feature within the nuclei of some of the neoplastic cells caught the eye of a few of the participants. Infrequently, neoplastic mesothelial cells have what look like irregularly shaped, eosinophilic, intranuclear inclusion bodies (INIBs). This is an uncommon, but documented, feature of certain mesotheliomas in humans that can be seen both cytologically and histologically, particularly in adenomatoid and epithelioid forms.5,6 INIBs have also been seen, albeit rarely, in laboratory hamsters and rats infected with SV40 that subsequently developed mesothelioma.21 INIBs are reported, also rarely, in both cattle and dogs with mesothelioma associated with asbestos exposure, although the significance of those inclusions is unknown. Lastly, INIBs can be a rare feature of reactive mesothelial cells as well, making their presence challenging to interpret, but may prompt pathologists to assess for viral or asbestos-related causes.21
The last notable point in this case discussion focused on other possible differentials for this lesion in equids, which prompted a quick conversation on equine herpesvirus-5, the cause of equine multinodular pulmonary fibrosis in horses. In donkeys, asinine herpesvirus-5 causes a similar syndrome and, if this tissue had been from the lungs, this virus would have been a good differential to put on the list.
Mesothelioma was first described by Bichat in 1827. Mesothelial cells originate from the embryonic lateral plate mesoderm, forming a protective epithelial lining known as the mesothelium for the pleural, pericardial, and peritoneal spaces.3 There are two layers to the lateral plate mesoderm that form during development. The dorsal layer, called the somatic mesoderm, is associated with the overlying ectoderm, while the ventral layer, termed the splanchnic mesoderm, is associated with the underlying endoderm.3 The splanchnic mesoderm eventually forms the visceral mesothelium on organs, whereas the somatic mesoderm develops into the parietal mesothelium of the body wall.
Mesothelial cells are somewhat unique amongst cell types for their dual immunoreactivity to both pancytokeratin and vimentin. During development, mesothelial cells differentiate from their mesodermal precursors, developing features of both epithelial and mesenchymal cells. With certain stimuli, mesothelial cells can undergo epithelial-to-mesenchymal transition (EMT) into other cell types, such as myofibroblasts, smooth muscle cells, and/or endothelial cells.3 This ability highlights their roles in repair and tissue formation following injury or inflammation.
While this immunohistochemistry (IHC) profile can be a useful feature for diagnosis, there are other neoplasms that can express dual positivity for pancytokeratin and vimentin when neoplastic cells undergo EMT. As mentioned by the contributor, this has been reported in metastases from both ovarian and renal carcinomas.16 It has also been documented in melanomas and aggressive metaplastic mammary carcinomas in humans.9 The absence of an additional primary neoplasm can help rule out other tumors, but there are other IHCs utilized in veterinary literature to assist in definitively diagnosing mesotheliomas. The JPC performed in-house calretinin and Wilms Tumor 1 (WT1) immunohistochemistry on this case post-conference, as both of these markers have been utilized in animal species to diagnose mesothelioma successfully.20 Unfortunately, neither of these IHCs worked on the donkey tissue in this case.
References:
- Davis CR, Valentine BA, Gordon E, McDonough SP, Schaffer PA, Allen AL, & Pesavento P. Neoplasia in 125 donkeys (Equus asinus): literature review and a survey of five veterinary schools in the United States and Canada. JVDI. 2016;28(6):662–670.
- Glickman LT, Domanski LM, Mawire TG, Dumxzig RR, & Churgs A. Mesothelioma in Pet Dogs Associated with Exposure of Their Owners to Asbestos. Environmental Research. 1983;32.
- Hiriart E, Deepe R, Wessels A. Mesothelium and Malignant Mesothelioma. Journal of Developmental Biology. 2019;7(2):7
- Husain AN, et al. Guidelines for pathologic diagnosis of Malignant Mesothelioma: 2017 Update of the consensus statement from the International Mesothelioma Interest Group. Archives of Pathology and Laboratory Medicine. 2018;142(1):89–108)
- Kadota K, Suzuki K, Colovos C, Sima CS, Rusch VW, Travis WD, Adusumilli PS. A nuclear grading system is a strong predictor of survival in epitheloid diffuse malignant pleural mesothelioma. Mod Pathol. 2012;25(2):260-71.
- Kawai T, Kawashima K, Serizawa H, Miura H, Kyeongil K. Adenomatoid mesothelioma with intranuclear inclusion bodies: a case report with cytological and histological findings. Diagn Cytopathol. 2014;42(5):436-40.
- Kim SM, Oh Y, Oh SH, & Han JH. Primary diffuse malignant peritoneal mesothelioma in a striped skunk (Mephitis mephitis). Journal of Veterinary Medical Science. 2016;78(3):485–487
- Krametter R, Bago Z, Floeck M, Baumgartner W. Abdominal mesothelioma in a goat. N Z Vet J. 2004;52(5):293-6.
- Kuburich NA, Kiselka JM, den Hollander P, Karam AA, Mani SA. The cancer chimera: Impact of vimentin and cytokeratin co-expression in hybrid epithelial/mesenchymal cancer cells on tumor plasticity and metastasis. Cancers (Basel). 2024;16(24):4158.
- Lopez A, et al. Respiratory system, Thoracic Cavities, Mediastinum, and Pleurae. In: Zachary JF, ed. Pathologic Basis of Veterinary Disease. 6th ed. St. Louis, MO: Mosby Elsevier; 2016: 597-598.
- McCleery B, Jones MP, Manasse J, Johns S, Gompf RE, Newman S. Pericardial Mesothelioma in a Yellow-naped Amazon Parrot (Amazona auropalliata). J Avian Med Surg. 2015;29(1):55-62.
- Misdorp W. Congenital tumours and tumour-like lesions in domestic animals. 1. Cattle. A review. Vet Q. 2002;24(1):1-11.
- Misdorp W. Tumours in calves: comparative aspects. J Comp Pathol. 2002;127(2-3):96-105
- Moberg HL, Gramer I, Schofield I, Blackwood L, Killick D, Priestnall SL, Guillén A. Clinical presentation, treatment and outcome of canine malignant mesothelioma: A retrospective study of 34 cases. Vet Comp Oncol. 2022;20(1):304-312.
- Movassaghi AR, Maleki M, & Khanzadi S. Primary pericardial mesothelioma in a sheep. Comparative Clinical Pathology. 2009;18(4):459–461.
- Munday JS, Löhr CV, and Kiupel M. Tumors of the Alimentary tract - Tumors of the peritoneum and retroperitoneum. In: Meuten DJ, ed. Tumors in Domestic Animal, 5th Ames, IA: John Wiley and Sons Inc; 2017:592-595.
- Passantino G, Sassi E, Filippi I, Serata V, Tinelli A, Zizzo N. Thoracic and Abdominal Mesothelioma in an Older Horse in Lazio Region. Animals (Basel). 2022;12(19):2560.
- Schlueter AH, Dehghanpir SD, Boudreaux B, Robinson C, Menk P Lima JC, Langohr IM. Feline mesothelioma: case report and review of cytologic, immunocytochemical, histopathologic, and immunohistochemical findings. J Vet Diagn Invest. 2021;33(4):753-757.
- Souza Fde A, de Carvalho CJ, de Almeida HM, Pires LV, Silva Ldos S, Costa FA, Silva SM. Peritoneal mesothelioma in a jaguar (Panthera onca). J Zoo Wildl Med. 2013;44(3):737-9.
- Stoica G, Cohen N, Mendes O, Kim HT. Use of immunohistochemical marker calretinin in the diagnosis of a diffuse malignant metastatic mesothelioma in an equine. J Vet Diagn Invest. 2004;16(3):240-3.
- Testa JR, Berns A. Preclinical Models of Malignant Mesothelioma. Front Oncol. 2020;10:101.
- Uzal FA, Plattner BL, Hostetter JM. Alimentary system. In: Maxie MG, ed. Jubb, Kennedy, and Palmer’s Pathology of Domestic Animals, Vol 2, 6th ed. St. Louis, MO: Elsevier; 2016:256-7.